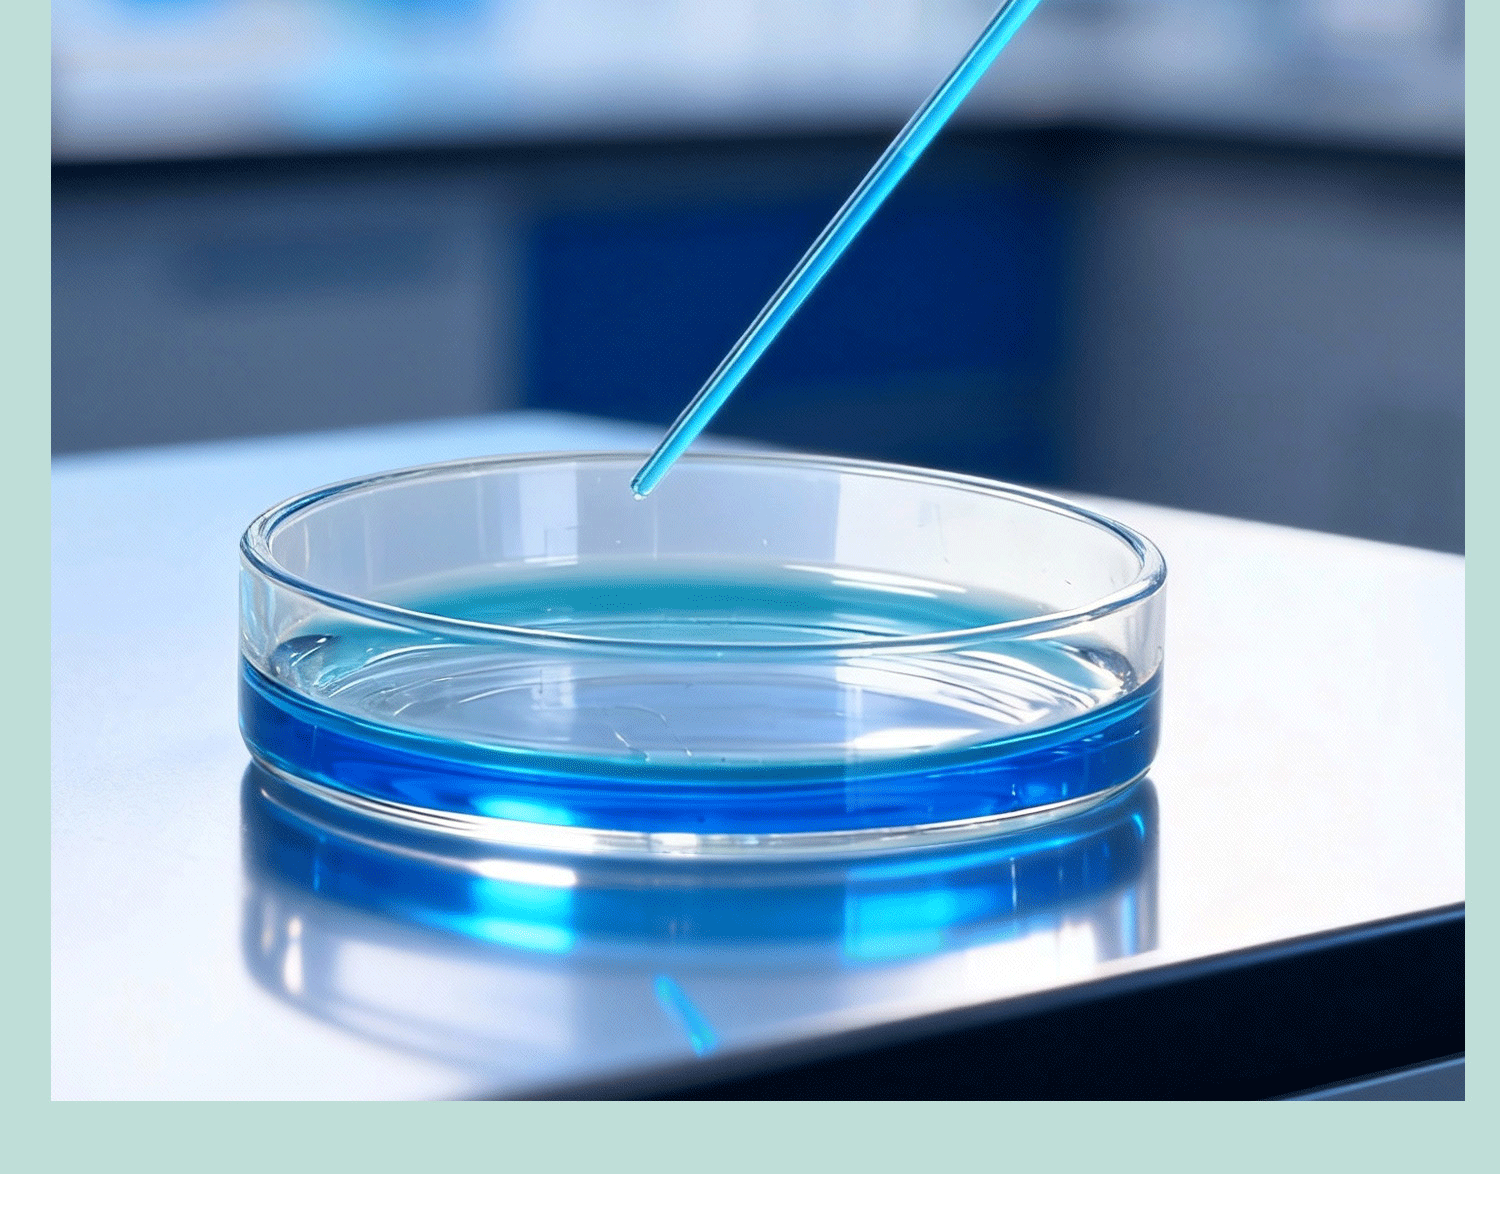

Капилляр точности капилляра точки плавления капилляра забора боросиликатного стекла
Продано за 30 дней:
79 шт.
Всего продаж:
19999795 шт.
Минимальное количество для заказа:
1 шт.
Капилляр точности капилляра точки плавления капилляра забора боросиликатного стекла
от 95.20 ₽ за 1 шт.
-21%
95.20 ₽
Доставка по Китаю включена в цену
Оптом
от 1 шт.
95.20 ₽
Описание

Характеристики
Технические характеристики:
Точечный образец 0,1*100 мм (1000 шт/бочка); Точечный образец 0,3*100 мм (1000 шт/бочка); Точечный образец 0,4*100 мм (1000 шт/бочка); Образец 0,5*100 мм (1000 шт/баррель); Образец 0,3*200 мм (1000 шт./Баррель); Образец 0,5*200 мм (1000 шт/баррель); Точка плавления 0,9*80 мм (500 шт/баррель); Точка плавления 0,9*100 мм (500 шт/баррель); Точка плавления 0,9*120(500 ПК/бочонок); Точка плавления 0,9*150(500 ПКС/Баррел); Точка плавления 0,9*160(500 ПК/баррель); Точка плавления 0,9*180(500 ПК/бочонок); Точка плавления 0,9*200(500 ПКС/Баррел); Уплотнение с температурой плавления 0,9*80 мм (500 шт/бочка); Уплотнение с температурой плавления 0,9*100 мм (500 шт/бочка); Уплотнение с температурой плавления 0,9*120 мм (500 шт/бочка); Уплотнение с температурой плавления 0,9*150 мм (500 шт/бочка); Уплотнение с температурой плавления 0,9*160 мм (500 шт/бочка); Уплотнение с температурой плавления 0,9*180 мм (500 шт/бочка); Уплотнение с температурой плавления 0,9*200 мм (500 шт/бочка)
Марка:
ТС
Вместимость:
Точечный образец 0,1*100 мм (1000 шт/бочка)
Цена за единицу товара:
6.80
О продавце
Имя:
Оценка сервиса:
4.0
Оценка логистики:
3.4
Оценка споров и жалоб:
5.0
Оценка предложения:
3.6
Оценка консультации:
2.0
repeatPurchasePercent:
0.4496561754666154
afterSalesExperienceScore:
3.6
collect30DayWithin48HPercent:
1.0
qualityRefundWithin30Day:
0.0014727540500736377

Капилляр точности капилляра точки плавления капилляра забора боросиликатного стекла
95.20 ₽
95.20 ₽




























